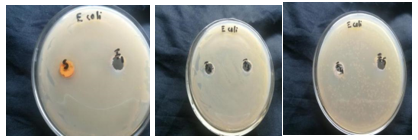

We use cookies to ensure our website works properly and to personalise your experience. Cookies policy

We use cookies to ensure our website works properly and to personalise your experience. Cookies policy
Department of Pharmaceutics, St, James College of Pharmaceutical Sciences, Chalakudy 680307, Thrissur, Kerala, India.
The integration of traditional medicine with nanotechnology offers innovative strategies to combat Skin and Soft Tissue Infections (SSTIs) and address the growing challenge of antimicrobial resistance. Glycyrrhetinic acid (GLA), a pentacyclic triterpenoid derivative extracted from the rhizomes of Liquorice (Glycyrrhiza glabra L.) possesses a range of pharmacological properties, including calmative, anti-inflammatory, antiallergic, and anti-tumor effects. However, its low solubility and dissolution rate limit its pharmaceutical application to overcome these limitations, a proniosomal gel formulation of Glycyrrhetinic acid was developed and evaluated. Proniosomal gels, a recent vesicular drug delivery system for transdermal administration, are composed of non-ionic surfactants, cholesterol, and lecithin. They are dry preparations that, upon hydration, form niosomes, thereby enhancing the solubility and bioavailability of poorly water-soluble drugs and reducing the physical stability problems of conventional niosomes. Five different formulations (F1-F5) were prepared using the Coacervation phase separation method with various surfactants (Span 20, Span 60, and Tween 80). The formulations were characterized for particle size, zeta potential, viscosity, Spreadability, drug content, encapsulation efficiency, in vitro drug release, and stability. Formulation F4 demonstrated superior characteristics across all tests. In vitro antimicrobial studies revealed that F4 exhibited better antibacterial activity against Staphylococcus aureus (S. Aureus) and Escherichia coli (E. coli) , though no antifungal activity was observed against Candida albicans. The study concludes that the proniosomal gel containing the optimal combination of surfactants is a promising and effective alternative transdermal carrier for Glycyrrhetinic acid.
In the olden days for the treatment of acute or chronic disorders, drugs are delivered to patients in the form of various pharmaceutical dosage forms like tablet, capsules, syrup, pills, suppositories etc. So therefore achieving the effective therapeutic range which is essential for the treatment, it is often necessary to take this type of drug delivery system several times a day. Nowadays the most widely used route for the administration of the drugs is transdermal because it is more convenient over the other conventional dosage forms like no gastric irritation, reduces number of doses, high patient compliance and enhanced bio availability. One of the most important ways for non-invasive delivery of drugs is human skin. But some high molecular weight (>500 Dalton) compounds can't cross the skin. Such type of compounds requires some novel techniques. Vesicular systems like liposomes, niosomes, proniosomes are mainly used for this purpose. They have the ability to transfer high molecular weight compounds across the skin .(1)
For the advanced drug delivery, these vesicular systems are receiving a great importance as a drug carrier. The encapsulation of the drugs in these vesicular structures helps to enhance duration of drugs in the systemic circulation and reduces the serious side effects. In short, vesicular drug delivery is one of the approaches which encapsulate the drug. The advantage of this system over other conventional dosage forms is their particulate nature, which acts as drug reservoir. It was found that modified vesicles had properties that successfully delivered drugs by doing few modifications in pattern and drug release (2). Drug delivery systems using colloidal particulate carriers (such as liposomes or niosomes) have proved to possess distinct advantages over the conventional dosage forms because the particles can acts as drug reservoirs, can carry both hydrophilic and hydrophobic drugs, and modification of the particle composition or surface can adjust the drug release rate and/or affinity for the target site .(3). One of the most important novel drug delivery system is niosomes, in which they are encapsulated inside the vesicles. Niosomes vesicles are formed by hydrating the mixture of non-ionic surfactants and cholesterol. Proniosomes are defined as dry formulations of water soluble carrier particles coated with non-ionic surfactants, which upon hydration with water form niosomes. They have the potential advantages over other conventional dosage forms like niosomes and liposomes. Proniosome is a dry product which could be easily rehydrated just before the use. It helps to avoid many disadvantages of the niosomal dispersions like physical (aggregation, fusion, leakage) and chemical (oxidation hydrolysis) instability problems. The ease of preparation, transportation and storage makes dry niosomes (proniosomes) a promising industrially useful product. (4)
MATERIALS AND METHODS
1.PREFORMULATION STUDIES
a) DRUG EXCIPIENT COMPATIBILITY STUDY BY FOURIER TRANSFORM INFRARED SPECTROSCOPY (FTIR)
The FT-IR studies are used to determine the functional groups in the physical mixture. The pure drug of Glycyrrhetinic acid was mixed with IR grade potassium bromide in a ratio of 1:100 and the pellets were prepared by applying pressure in the KBr press. The pellets were then scanned over the range of 4000-400cm-1 in FTIR spectrometer. (5)
b) IDENTIFICATION OF GLYCYRRHETINIC ACID
The solution of Glycyrrhetinic acid containing the concentration 10µg/ml was prepared in HPLC grade methanol and UV spectrum was taken using UV/Visible double beam spectrophotometer The solutions was scanned in the range of 200-400 nm.
c) PREPARATION OF STANDARD CALIBRATION CURVE OF GLYCYRRHETINIC ACID
10 mg of Glycyrrhetinic acid was accurately weighed and transferred into 10 ml of volumetric flask. It was dissolved and diluted to volume with HPLC grade methanol to give stock solution containing 1000µg/ml. From the above stock solution 1 ml was taken in 10 ml volumetric flask and make up the volume upto 10 ml with methanol to give a stock solution containing 100µg/ml.
The standard stock solution was then serially diluted with methanol to 5,10,15,20,25,30 µg/ml. The absorbance of the solution was measured against methanol as blank at 254nm using UV spectrophotometer. The absorbance values were plotted against concentration (µg/ml) to obtain the standard calibration curve.
2) DETERMINATION OF SOLUBILTY
Solubility is the property of a solid, liquid or gaseous chemical substance called solute to dissolve in solid, liquid or gaseous solvent to form a homogeneous solution of the solute in the solvent. The solubility of substance fundamentally depends on the solvent used as well as on temperature and pressure. Any drug to be absorbed must be present in the form of solution at the site absorption.
Various techniques are used for the enhancement of the solubility of poorly soluble drugs which include physical and chemical modification of drug and other method like particle size reduction, crystal engineering and so far. Selection of solubility improving methods depends on drug property, site of absorption and required dosage form characteristics.
The extend of solubility of substance in a specific solvent is measured as the saturation concentration. It will be performed with an orbital shaker. The saturation solubility was determined by adding excess of glycyrrhizin acid in 20 ml distilled water and with shaking at 37±0.5°C. After 24 hrs suspension was filtered and analysed spectrometrically at 254nm.
Similarly, solubility of Glycyrrhetinic acid in various solvents like phosphate buffer of pH 7.4 and methanol was also determined. (6)
3)FORMULATION OF GLYCYRRHETINIC ACID PRONIOSOMAL SUSPENSION In this method accurately weighed quantity of drug along with surfactant, cholesterol and lecithin was taken in a wide mouth glass vessel. Then add 2 ml of solvent (ethanol) and heat the mixture in a water bath at a temperature of 50-60°C. The open end of the glass vial was covered with a lid to prevent the evaporation of the solvent. To this mixture add 8 ml of phosphate buffer pH 7.4. Warm the mixture over a water bath at 50-60°C until the drug was completely dissolved in the surfactant mixture. The proniosomal gel is formed by either cooling the mixture at room temperature or add a suitable gelling agent (1.5% carbopol) to the heated mixture and cool it on ice bath. (7)
Table 1: Formulation of Glycyrrhetinic acid loaded proniosomal suspension by coacervation phase separation method
|
Formulation (Qty in mg) |
Drug |
Span 60 |
Span 20 |
Tween 80 |
Cholesterol |
Lecithin |
|
F1 |
10 |
100 |
|
|
10 |
100 |
|
F2 |
10 |
|
100 |
|
10 |
100 |
|
F3 |
10 |
|
|
100 |
10 |
100 |
|
F4 |
10 |
|
50 |
50 |
10 |
100 |
|
F5 |
10 |
50 |
|
50 |
10 |
100 |
4) CHARACTERIZATION OF GLYCYRRHETINIC ACID PRONIOSOMAL SUSPENSION
Determination of particle size
The particle size (PS) of the prepared proniosomal suspension was measured using Malvern Nano ZS zetasizer. All the measurements were performed in triplicate. (8)
Zeta potential analysis of formulated glycyrrhetinic acid proniosomal suspension
The zeta potential is caused by the net electric charge contained within the region bounded by the slipping plane and also depends on the location of that plane. The determination of the zeta potential of proniosomes is essential as it gives an idea about the physical stability of the proniosomes.
5) PREPARATION OF PRONIOSOMAL GEL
About 2 ml of PN suspension was added to carbopol 934 (1.5% w/v). The gel was sonicated for 15 min and kept overnight to remove air bubbles. (9)
6) CHARACTERISATION OF PRONIOSOMAL GEL
Physical appearance and homogeneity
The physical appearance and homogeneity were tested by visual observation. (10)
Viscosity
Viscosity was measured using Brookfield Viscometer with T-shaped spindle no.62 at 2rpm at 25?C within time interval of 1 minute.
Measurement of pH
The pH measurements were performed in triplicate by digital pH meter. The electrode was first calibrated with pH 4.0 and pH 7.0 solution. Then pH of each formulation was measured. (11)
Spreadability
Spreading coefficient will be determined by taking two glass slides having same dimension. The proniosomal formulation (F1) was placed at lower slide and upper slide is tied with a particular weight. Then upper slide is placed on the lower slide so that the proniosomal gel preparation is sandwiched between these slides. The time in seconds required by the top slide to separate from ground slide was noted. Same procedures will be followed by formulation F2, F3 , F4 & F5 formulations. (12)
It is calculated by using the formula :
S = M . L / T
Where, M = Weight tied to upper slide
L = Length of glass slides
T = Time taken to separate the slides
Drug content of proniosomal gel
The drug content was determined by taking 2gm of proniosomal gel sample from container and dissolved in 100 ml ethanol. From this I ml solution was diluted up to 10 ml with ethanol. Then the absorbance was measured by UV spectrophotometer against blank at λ max 254 nm and the drug content was determined. The same procedure is carried out for remaining formulations. (13)
Encapsulation Efficiency
Encapsulation efficiency of proniosomal gel will be determined by UV Spectrometry. 0.2g of proniosomal gel will be taken and mixed with 10 ml of phosphate buffer pH 7.4, The aqueous suspension will be sonicated in a bath sonicator for 10 minutes. Then the suspension is centrifuged at 18000 rpm at 5?C for 40 minutes. The supernatant was separated and concentration of unentrapped drug was determined by UV analysis against blank at 254nm. (14)
EE (%) = Concentration of the total drug- Concentration of the free drug × 100
Concentration of the total drug
7) IN-VITRO DRUG RELEASE STUDY OF PRONIOSOMAL GEL
The in-vitro drug release from the proniosomal vesicles will be determined by using the following methods like Dialysis tubing, Reverse dialysis, Franz diffusion cell. Here the permeation of the drug from the proniosomal formulation was determined by using a dialysis bag as a donor compartment. The dialysis bag was filled with proniosomal gel and immersed in a beaker containing 400 ml phosphate buffer solution which act as a receptor compartment. The beaker was placed over a magnetic stirrer at 100 rpm and maintained at 37±1? C. 3ml of the sample was withdrawn from the receptor compartment and replaced it with fresh receptor solution at the time interval of 1 to 6 hrs. The sink condition should be maintained throughout the procedure. Then the samples should be analyzed by UV spectrophotometry at 254 nm. (15)
8)STABILITY STUDIES OF GLYCYRRHETINIC ACID LOADED PRONIOSOMAL GEL
To determine the stability, the optimized proniosomal formulation was kept at different temperatures in an air tight container as per ICH guidelines. The optimized formulation was first kept at refrigerated temperature (2-8?C) and then at room temperature for a period of 2 months. After 2 months the physical appearance, vesicle size and drug content is evaluated again. (16)
9)STUDY OF IN-VITRO ANTIMICROBIAL ACTIVITY OF GLYCYRRHETINIC ACID LOADED PRONIOSOMAL GEL
A) Antibacterial activity
The test was carried out by using nutrient agar medium. Nutrient agar medium was prepared and transferred to previously sterilized petri dish.Strain used is Staphylococcus aureus, Escherichia coli
Antibacterial screening by spread plate method
Nutrient agar medium was prepared and sterilized. 20 ml of the media were poured into the sterile glass plates having internal diameter of 8.5 cm. Then the plates are allowed to gel for 1 hour.After the complete solidification of the medium, 0.2 ml of bacterial suspension was poured and spread evenly over the plates.6 wells were created with a sterile cork borer having 6mm diameter.One well was made for standard drug and labelled it as 'standard'. Its zone of inhibition was measured to compare with the zone of inhibition of the test sample.Carefully place the proniosomal formulations (F1, F2, F3, F4 and F5) and standard (Curcumin) into each well. All the plates were kept at room temperature for effective diffusion of the standard drug and samples. Plates were incubated at 37±0.5°C for 24 hours. Then measure and record the diameter of the zone of inhibition. (17)
Preparation of media and sterilization of the media:
Suspend 16.25gm of sabouraud's agar in 250 ml distilled water and boiled the suspension to uniform mixing until the clear solution appeared. Then adjust the pH to 5.4±0.2. Then the sterilization was done by autoclaving at 15lbs pressure (121°C) for 15 minutes.The organism used was Candida albicans, Samples used was Ketoconazole (Standard) and Proniosomal formulations (F1, F2, F3, F4,F5)
Antifungal screening by spread plate method
In this method , liquefied medium was prepared. 20 ml of the media were poured into the sterile glass plates having internal diameter of 8.5 cm.Care was taken for the uniform thickness of the layer of medium. Then the plates are allowed to gel for 1 hour. After the complete solidification of the liquefied medium, 0.2 ml of fungal suspension was poured and spread evenly over the plates. 6 wells were created with a sterile cork borer having 6mm diameter.One well was made for standard drug and labelled it as 'standard'. It’s zone of inhibition was measured to compare with the zone of inhibition of the test sample.Carefully place the proniosomal formulations (F1, F2, F3, F4 and F5) and standard (Ketoconazole) into each well. Plates were incubated at 37±0.5°C for 48 hrs. Then measure and record the diameter of the zone of inhibition.(18)
RESULTS AND DISCUSSION
1)PREFORMULATION STUDIES
a)DRUG – Excipient compatibility study by fourier transform infrared spectroscopy ( FT-IR)
FT-IR analysis provides information on chemical interactions taking place between drug and excipients, favouring the development of stable formulation prior to the study.Pure drug glycyrrhetinic acid, soya lecithin, physical mixture of both drug and soya lecithin were subjected to FT-IR analysis. The characteristic peaks of individual drug and excipients remain intact in the physical mixture which indicate the absence of drug-excipient interaction in the formulation.

Fig 1:FT-IR spectrum of Glycyrrhetinic acid Fig 2:FT-IR spectrum of Soya lecithin
Fig 3: FT-IR spectrum of drug + soya lecithin
Table 2: FT-IR Interpretation
|
Sl. No. |
Name Of Components |
Frequency (Cm-1) |
Pure Drug (Cm-1) |
Soya Lecithin (Cm-1) |
Drug With Soya Lecithin (Cm-1) |
|
1 |
C=O Stretch |
1730-1700 |
1729.26 |
1739.87 |
1729.26 |
|
2 |
C=C Stretch |
1658-1648 |
1648.24 |
1643.42 |
1644.39 |
|
3 |
O-H Stretch |
3500-3200 |
3455.62 |
|
3452.73 |
|
4. |
N-H Stretch |
3550-3060 |
|
3445.01 |
|
The combination spectrum of drug and excipients showed no change in the peak values corresponding to the functional groups of drugs when combined with excipients. That confirms the stability of formulation.
b) UV-VISIBLE SPECTROSCOPIC ANALYSIS
λmax and calibration curve of glycyrrhetinic acid was plotted.
The λmax of pure drug glycyrrhetinic acid in methanol was found to be 254nm.

Fig 4: Determination of λmax
c) CONSTRUCTION OF STANDARD CURVE OF GLYCYRRHETINIC ACID
Calibration curve for a series of concentration in the range of 10 -50 μg/ml.It was found to be linear and hence suitable for estimating the drug.
Table 3: Absorbance Vs Concentration of Glycyrrhetinic acid
|
Sl No. |
Concentration (µg/Ml) |
Absorbance (At 254 Nm) |
|
1 |
0 |
0 |
|
2 |
10 |
0.1 |
|
3 |
20 |
0.21 |
|
4 |
30 |
0.32 |
|
5 |
40 |
0.4 3 |
STANDARD CALIBRATION CURVE OF GLYCYRRHETINIC ACID

Fig 5: Standard calibration curve of Glycyrrhetinic acid
2. DETERMINATION OF SOLUBILITY
The solubility of Glycyrrhetinic acid was determined by orbital shaker method by using different solvents and the result are shown as below.
Table 4: Solubility analysis of Glycyrrhetinic acid
|
Solvents |
Solubility |
|
Distilled water |
Insoluble |
|
Phosphate buffer of ph 7.4 |
Insoluble |
|
Methanol |
Soluble |
Solubility of Glycyrrhetinic acid was determined by using various solvents like distilled water, Phosphate buffer of pH 7.4, and methanol.Glycyrrhetinic acid is soluble in methanol.It is insoluble in distilled water and phosphate buffer.
3. FORMULATION OF GLYCYRRHETINIC ACID LOADED PRONIOSOMAL SUSPENSION
The proniosomal formulations were prepared by mixing accurately weighed quantities of surfactants ( Span 60, Span 20, Tween 80 ), cholesterol, soya lecithin, drug (Glycyrrhetinic acid) and ethanol. Then heat this mixture in a water bath at a temperature of 50-60°C. The open end of the glass vial is covered with a lid to prevent the evaporation of the solvent. Phosphate buffer pH 7.4 was added to this mixture and warm the solution over a water bath at 50-60°C until the drug dissolved completely in the surfactant mixture. The mixture thus obtained is sonicated using probe sonicator for 2hrs to obtain proniosomal suspension.
4. CHARACTERISATION OF GLYCYRRHETINIC ACID PRONIOSOMAL SUSPENSION
Determination of particle size

Fig 6: Particle size of formulations
Table 5: Particle size (nm)
|
Formulation |
Z average (D. NM) |
|
F1 |
1510 |
|
F2 |
702.4 |
|
F3 |
477.9 |
|
F4 |
236.1 |
Zeta potential analysis of formulated glycyrrhetinic acid proniosomal suspension

Fig 7: Zeta potential values of formulations
Table 6: Zeta potential (mv)
|
Formulations |
Zeta potential(mV) |
|
F1 |
-40.7 |
|
F2 |
-22.2 |
|
F3 |
-24.9 |
|
F4 |
-19.5 |
|
F5 |
-18.3 |
5.FORMULATION OF GLYCYRRHETINIC ACID LOADED PRONIOSOMAL GEL BY COACERVATION PHASE SEPARATION METHOD

Fig 8: Preparation of proniosomal gel
Prepared Formulations

Fig 9: Prepared formulations
6.CHARACTERISATION OF PRONIOSOMAL GEL
Physical Appearance of Proniosomal gel
The table shows the colour and physical state of each formula.The results shows that the formulation FI, F2, F3 have creamish yellow color, F4 & F5 have white colour. All the proniosomal formulations were semi-solid in appearance with smooth homogeneous nature. The consistency and homogeneity was found to be excellent for F4 and F5 and good for F1, F2 and F3. And there is no phase separation for all the five formulations
Table 7: Physical appearance of proniosomal gel
|
Formulation |
Colour |
Physical state |
Homogeneity |
Consistency |
Phase separation |
|
F1 |
Creamish yellow |
Semi-solid |
Good |
Good |
No |
|
F2 |
Creamish yellow |
Semi-solid |
Good |
Good |
No |
|
F3 |
Creamish yellow |
Semi-solid |
Good |
Good |
No |
|
F4 |
White |
Semi-solid |
Excellent |
Excellent |
No |
|
F5 |
White |
Semi-solid |
Excellent |
Excellent |
No |
Measurement of pH
The pH of the each formulation helps to determine the possibility of side effects when administered it as in-vivo. The pH of the prepared proniosomal formulations F1, F2, F3, F4 and F5 was determined by using the digital pH meter and is expressed in the graph below. The pH of all formulation was found to be in the range of 4.5- 5.7.These values comes under the normal skin pH conditions and does not produce any skin irritation.

Fig 10: Determination of pH of proniosomal gel
Determination of Viscosity
The viscosity of the formulated proniosomal gel of Glycyrrhetinic acid was determined by Brook field viscometer. The measurement of viscosity helps to determine the optimum consistency of each formulation. Viscosity of the formulations F1, F2, F3, F4 and F5 were determined. And as per the results, the formulation F4 and F5 was found to be having considerable viscosity than F1, F2 and F3 formulations.
Table 8: Determination of viscosity of Glycyrrhetinic acid loaded proniosomal gel
|
Formulation |
Viscosity (Centipoise) |
|
F1 |
43221±1.2 |
|
F2 |
44588±1.5 |
|
F3 |
45447±0.23 |
|
F4 |
35321±0.67 |
|
F5 |
31372±0.53 |
Spreadability
Spreadability is defined as ease of spreading or being spread. The spreadability indicates that the proniosomal gel is easily spreadable by applying small amount of force. Spreadability test was carried out for all the formulations. The spreadability is one of the most important factor which shows the behaviour of proniosomal gel when it comes out from the tube. The spreadability of F1, F2, F3, F4 & F5 formulation were performed and represented below in a graph. F4 & F5 formulation was found to be having more spreadability than F1, F2 & F3.

Fig 11: Determination of Spreadability of proniosomal gel
Drug content
Drug content in the proniosomal gel was confirmed to assure uniformity in dosages .The results are reported in graphical manner. The drug content of the prepared Proniosomal gel was estimated UV spectrophotometry at 254 nm. The drug content was found to be in the range of 70% to 90%.

Fig 12: Drug content of Glycyrrhetinic acid loaded proniosomal gel
Encapsulation Efficiency
Entrapment efficiency is one of the most important parameter in the development of vesicular formulations. The entrapment efficiency of the vesicles affects the stability of the vesicle which is highly depends upon the type of the surfactants used in the formulation and amount of both cholesterol and lecithin. The encapsulation efficiency of formulations F1, F2, F3, F4 and F5 were performed and expressed in a graph. The encapsulation efficiency (EE) is higher for formulation F4 than F1, F2, F3 and F5.

Fig 13: Encapsulation efficiency of Glycyrrhetinic acid loaded proniosomal gel
7) . IN-VITRO DRUG RELEASE OF GLYCYRRHETINIC ACID LOADEED PRONIOSOMAL GEL
The release of the drug from the proniosomal vesicles was estimated by using the dialysis membrane or dialysis bag. The in-vitro drug release study mainly used to calculate the uniform release of drug from the proniosomal vesicles. The cumulative % of each formulation was calculated and the result obtained from the study was expressed in a table and also expressed as a graph.
Table 9: In- vitro drug release study
|
Time in hrs |
F1 |
F2 |
F3 |
F4 |
F5 |
Pure drug |
|
0 |
0 |
0 |
0 |
0 |
0 |
0 |
|
1 |
7.02±0.23 |
7.32±0.47 |
6.85±0.22 |
8.45±0.32 |
7.51±0.44 |
6.45±0.67 |
|
2 |
12.21±0.67 |
13.94±0.61 |
11.76±0.39 |
21.53±0.43 |
16.34±0.62 |
10.34±0.64 |
|
3 |
24.45±0.85 |
24.62±0.71 |
20.09±0.5 |
36.28±0.62 |
32.42±0.71 |
13.08±0.49 |
|
4 |
33.12±0.43 |
37.76±0.48 |
31.86±0.78 |
51.53±0.71 |
40.11±0.76 |
23.08±0.35 |
|
5 |
46.21±0.27 |
49.23±0.44 |
43.54±0.31 |
64.21±0.87 |
52.25±0.58 |
35.21±0.41 |

Fig 14: Determination of in-vitro drug release of Glycyrrhetinic acid loaded proniosomal gel
8)STABILITY STUDY
Particle size analysis using zeta sizer after 3 months of storage at room temperature(25?C) & refrigerated temperature ( 4?C) was found to be within the range of 236 – 243 nm.
Table 10: Stability Study
|
Duration (Months) |
Particle size (nm) at room temperature(25?C) |
Particle size (nm) at refrigerated temperature(4?C) |
|
0 |
236.1 |
236.1 |
|
3 |
243 |
238 |
Based on the particles size determination using zeta sizer, stability study indicated that the formulated proniosomal gel was stable at room temperature and cold conditions under ambient conditions.
9)STUDY OF IN-VITRO ANTIMICROBIAL ACTIVITY OF GLYCYRRHETINIC ACID LOADED PRONIOSOMAL GEL
A) Antibacterial Study
Organisms used: Staphlococcus aureus, Escherichia coli
Table 11: Antibacterial Study
|
Formulations |
Zone of inhibition (mm) |
|
|
Against S. aureus |
Against E. coli |
|
|
Standard (Curcumin) |
28 |
Standard (Curcumin) |
|
F1 |
18 |
11 |
|
F2 |
21 |
F2 |
|
F3 |
- |
F3 |
|
F4 |
23 |
F4 |
|
F5 |
21 |
F5 |

Fig 15: Effect of antibacterial activity of Glycyrrhetinic acid loaded proniosomal gel against S. aureus
Fig 16: Effect of antibacterial activity of Glycyrrhetinic acid loaded proniosomal gel against E. coli
B) Antifungal Study
Organism used: Candida albicans
Antifungal activity was not observed for the prepared proniosomal gel.
SUMMARY AND CONCLUSION
Formulation of Glycyrrhetinic acid loaded proniosomal gel using coacervation phase separation method was simple, not time consuming and obtain the proniosomes in nano size. Carbopol 934 at a concentration of 1.5% was found to be more suitable for formulating Proniosomal gel.The formulation F4 gave smaller vesicle (236.1 nm) than F1, F2,F3 and F5 formulations .In case of viscosity , considerable values obtained for formulations F4 and F5.In the drug content determination, the formulation F4 and F5 was found to be containing 86.11, 82.76 respectively. The encapsulation efficiency (EE) is higher for formulation F4 (89%) than F1,F2, F3 and F5.The in-vitro drug release study shows that the formulation F4 has considerably good drug release 75.23% comparable to F1,F2, F3 and F5 formulations.Glycyrrhetinic acid loaded proniosomal gel (F4) showed greater zone of inhibition against bacteria (both gram positive and gram negative ) Proniosomal gel (F4) was stable. The stability is more in refrigerated temperature than room temperature.The study concluded that the proniosomal gel containing span20:tween 80 (1:1) (F4) was found to be more effective than the other formulations. Proniosomes are better alternative to the liposomal vesicular system due to their greater physical, chemical stability . Owing to all these advantages proniosomes are widely investigated as drug carriers.However future experiments are going on in the field of proniosomes with wide variety of drugs having drawbacks for improved and effective therapy.So that the proniosomes are represented as a promising drug delivery system
REFERENCES




Haritha Unnikrishnan, Rinku Jayaprakash, Dineshkumar B., Krishna Kumar, Glcyrrhetinic Acid Proniosomal Gel: Invitro Antimicrobial Study, Int. J. of Pharm. Sci., 2025, Vol 3, Issue 11, 4532-4547 https://doi.org/10.5281/zenodo.17746441
 10.5281/zenodo.17746441
10.5281/zenodo.17746441